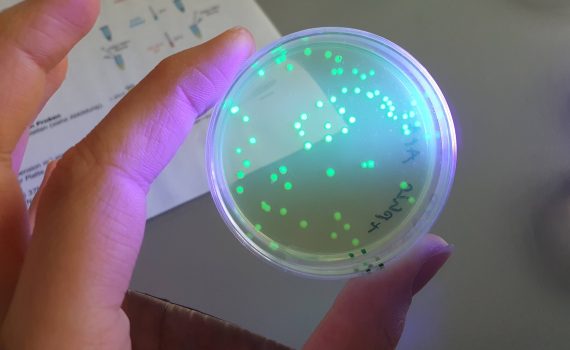

Am 4. Januar konnten wir endlich wieder ein Basketball-Turnier spielen. Es fand in der Max-Schmehling Halle statt. Hier kämpften wir […]
Archiv des Monats: Januar 2023
Die Arndter Volleyball-Mannschaft hat sich für das Berliner Finale qualifiziert! Damit hat wohl keiner gerechnet – am aller wenigsten die […]
Am 5. Januar 2023 besuchten wir als Biologie Leistungskurs das Gläserne Labor in Berlin Buch, wo wir an zwei verschiedenen […]
von Karla Mival, Q1 Am Samstag, 17.12.22 wurde unsere Idee des “Schneeballs” verwirklicht. Was als Projekt unserer Gruppe für den […]
von Max Ott, Q1 Im Rahmen des Musik-Zusatzkurses der elften Klasse hat sich unsere Gruppe, bestehend aus Valeria, Max, Fabian […]
Wir freuen uns, interessierte Eltern und Kinder, insbesondere der zukünftigen Jahrgangsstufe 7, am 14.1.2023 von 10:00 Uhr bis 13:00 Uhr […]
von Penelope, 8w Am Montagmorgen haben wir uns am Bahnhof Südkreuz getroffen und sind alle zusammen nach Wittenberg gefahren. Schon […]
Die Ausgabe 2022 kann ab dem 03. Januar 2023 auf der Webseite der Alten Arndter (www.alte-arndter.de) in der Rubrik „Dahlemer […]